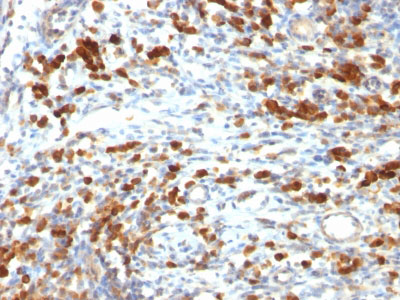

> Antigen, Antibodies, ELISA, Western Blot > Primary Antibody > Monoclonal Antibodies > CD79a (B-Cell Marker) Antibody - With BSA and AzideBrand |
Leading Biology | Catalog Number |
AMM01638G |
Product Type |
Monoclonal Antibodies | Field of Research |
|
Product Overview |
We constantly strive to ensure we provide our customers with the best antibodies. As a result of this work we offer this antibody in purified format.
We are in the process of updating our datasheets. If you have any questions regarding this update, please feel free to contact our technical support team.
This product is a high quality CD79a (B-Cell Marker) Antibody - With BSA and Azide.
|
||
Molecular Weight |
44kDa
|
||
Cellular Localization |
Antigen Cellular Localization:
Cell membrane; Single-pass type I membrane protein. Note=Following antigen binding, the BCR has been shown to translocate from detergent-soluble regions of the cell membrane to lipid rafts although signal transduction through the complex can also occur outside lipid rafts.
|
||
Host |
Mouse
|
||
Species Reactivity |
Human
|
||
Clone |
IGA/764
|
||
Isotype |
Mouse / IgG1, kappa
|
||
Symbol |
IGA, MB1
|
||
GeneID |
|||
UniProt ID |
|||
Function |
Required in cooperation with CD79B for initiation of the signal transduction cascade activated by binding of antigen to the B-cell antigen receptor complex (BCR) which leads to internalization of the complex, trafficking to late endosomes and antigen presentation. Also required for BCR surface expression and for efficient differentiation of pro- and pre-B-cells. Stimulates SYK autophosphorylation and activation. Binds to BLNK, bringing BLNK into proximity with SYK and allowing SYK to phosphorylate BLNK. Also interacts with and increases activity of some Src- family tyrosine kinases. Represses BCR signaling during development of immature B-cells.
|
||
Summary |
A disulphide-linked heterodimer, consisting of mb-1 (or CD79a) and B29 (or CD79b) polypeptides, is non-covalently associated with membrane-bound immunoglobulins on B cells. This complex of mb-1 and B29 polypeptides and immunoglobulin constitute the B cell Ag receptor. CD79a first appears at pre B cell stage, early in maturation, and persists until the plasma cell stage where it is found as an intracellular component. CD79a is found in the majority of acute leukemias of precursor B cell type, in B cell lines, B cell lymphomas, and in some myelomas. It is not present in myeloid or T cell lines. Anti-CD79a is generally used to complement anti-CD20 especially for mature B-cell lymphomas after treatment with Rituximab (anti-CD20). This antibody will stain many of the same lymphomas as anti-CD20, but also is more likely to stain B-lymphoblastic lymphoma/leukemia than is anti-CD20. Anti-CD79a also stains more cases of plasma cell myeloma and occasionally some types of endothelial cells as well.
|
||
Form |
Liquid |
||
Storage & Stability |
Store at +4°C short term. For long-term storage, aliquot and store at -20°C or below. Stable for 12 months at -20°C. Avoid repeated freeze-thaw cycles.
|
||
Applications |
IHC, IF, FC
|
||
Images |
Formalin-fixed, paraffin-embedded human Lymphoma stained with CD79a Monoclonal Antibody (IGA/764). |
||
Specification |
|||
Quantity |
|
||
| Select | Brand | Catalog No. | Product Name | Pack Size | Type | Field of Research | Specification | Quantity | Price(USD) | |
| 1 | Leading Biology | APG02467G | CCK4 / PTK7 Antibody (clone 4F9) | 50 μl | Monoclonal Antibodies |
|
$495.00 | Add Ask | ||
| 2 | Leading Biology | AMM04683G | GALT Antibody (clone 4C11) | 50 μg | Monoclonal Antibodies |
|
$545.00 | Add Ask | ||
| 3 | Leading Biology | AMM01402G | Vimentin (Mesenchymal Cell Marker) Antibody - With BSA and Azide | 50 ug | Monoclonal Antibodies |
|
$395.00 | Add Ask | ||
| 4 | Leading Biology | APR08280G | LTA4H / LTA4 Antibody (clone 9G8) | 50 μl | Monoclonal Antibodies |
|
$495.00 | Add Ask | ||
| 5 | Leading Biology | AMM00172G | CD1a / HTA1 (Mature Langerhans Cells Marker) Antibody - With BSA and Azide | 50 ug | Monoclonal Antibodies |
|
$395.00 | Add Ask | ||
| 6 | Leading Biology | AMM05750G | CEBPA Antibody | 100 μl | Monoclonal Antibodies |
|
$545.00 | Add Ask |
 Leading Biology Inc.
2600 Hilltop DR, Building G, B Suite C138
Richmond, CA, 94806
Tel: 1-661-524(LBI)-0262
Email: info@leadingbiology.com
Leading Biology Inc.
2600 Hilltop DR, Building G, B Suite C138
Richmond, CA, 94806
Tel: 1-661-524(LBI)-0262
Email: info@leadingbiology.com
Complete this form and click send to ask us a question, request a quote or simply say hello.

You have 0 item in your cart

You have 0 item in your inquiry list
